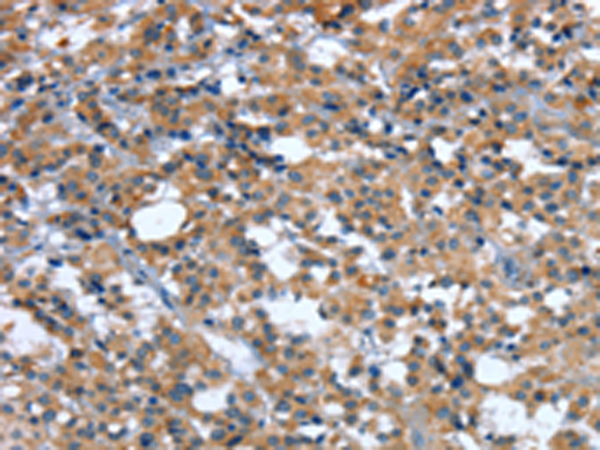

-
分类: 科研抗体货号: P11535别名: ENT1应用: WB,IHC反应种属: Human, Mouse, Rat
-
分类: 科研抗体货号: P11549别名: S10; HSAS; MASA; MIC5; SPG1; CAML1; CD171; HSAS1; N-CAML1; NCAM-L1; N-CAM-L1应用: IHC反应种属: Human, Mouse, Rat
-
分类: 科研抗体货号: P11528别名: MARC1; MOSC1应用: WB,IHC反应种属: Human
-
分类: 科研抗体货号: P11534别名: PSF1; RP4-691N24.2应用: IHC反应种属: Human, Mouse
-
分类: 科研抗体货号: P11548别名: LQT9; VIP21; LGMD1C; VIP-21应用: WB,IHC反应种属: Human
-
分类: 科研抗体货号: P11527别名: HCA4; LICS; NSE3; NDNL2; MAGEG1; MAGEL3应用: WB,IHC反应种属: Human, Mouse
-
分类: 科研抗体货号: P11567别名: CD286应用: IHC反应种属: Human
-
分类: 科研抗体货号: P11546别名: ACCN3; TNaC1; DRASIC; SLNAC1应用: IHC反应种属: Human
-
分类: 科研抗体货号: P11525别名: C15orf2应用: IHC反应种属: Human
-
分类: 科研抗体货号: P11565别名: P113; ISGF-3; STAT113应用: WB,IHC反应种属: Human

鄂公网安备42018502007531号
鄂公网安备42018502007531号

